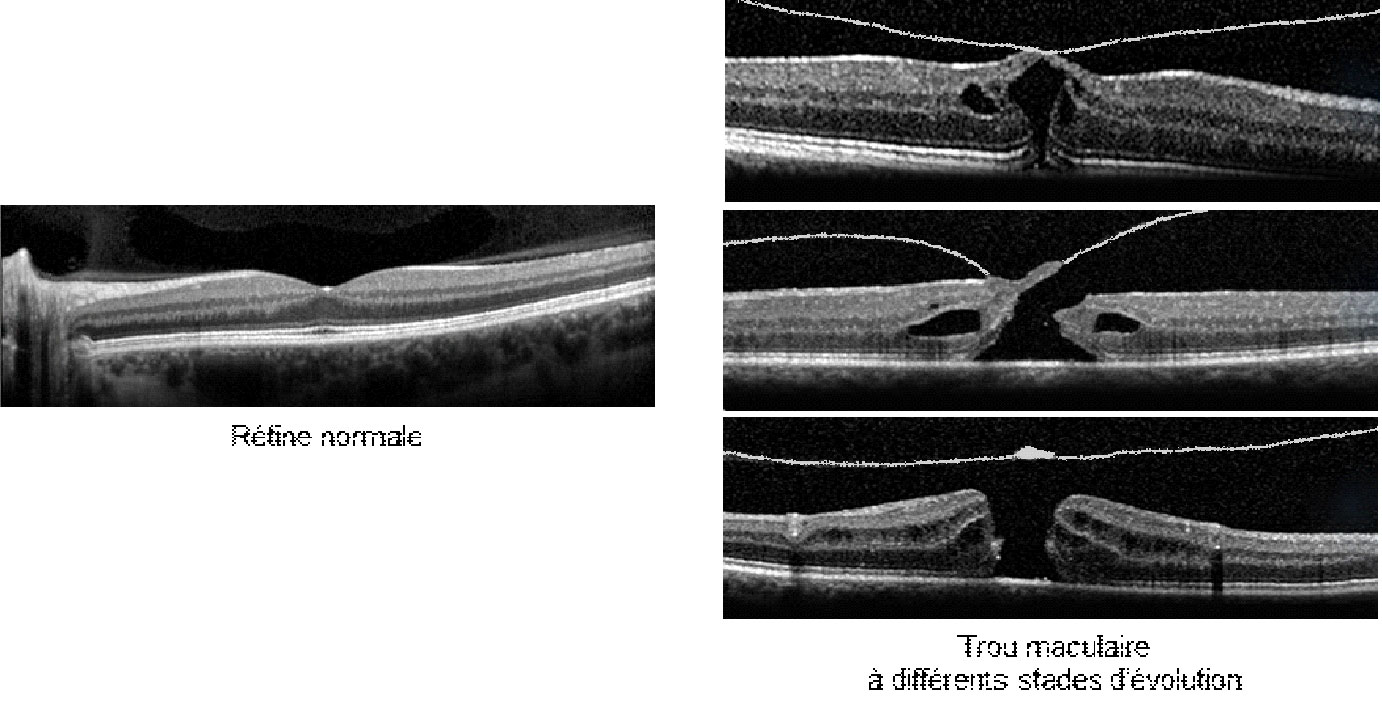
Trou-maculaire_img1

Trou maculaire
Mis à jour le 07/09/2022
Trou maculaire JTNDdWwlM0UlMEElM0NsaSUzRSUzQ2klMjBjbGFzcyUzRCUyMmZhJTIwZmEtY2hldnJvbi1yaWdodCUyMiUzRSUzQyUyRmklM0UlM0NhJTIwaHJlZiUzRCUyMiUyM1ByJUMzJUE5c2VudGF0aW9uJTIyJTNFUHIlQzMlQTlzZW50YXRpb24lM0MlMkZhJTNFJTNDJTJGbGklM0UlMEElM0NsaSUzRSUzQ2klMjBjbGFzcyUzRCUyMmZhJTIwZmEtY2hldnJvbi1yaWdodCUyMiUzRSUzQyUyRmklM0UlM0NhJTIwaHJlZiUzRCUyMiUyM3F1YW5kLW9wZXJlciUyMiUzRVF1YW5kJTIwb3AlQzMlQTlyZXIlMjB1biUyMHRyb3UlMjBtYWN1bGFpcmUlMjAlM0YlM0MlMkZhJTNFJTNDJTJGbGklM0UlMEElM0NsaSUzRSUzQ2klMjBjbGFzcyUzRCUyMmZhJTIwZmEtY2hldnJvbi1yaWdodCUyMiUzRSUzQyUyRmklM0UlM0NhJTIwaHJlZiUzRCUyMiUyM3F1ZWwtYmlsYW4lMjIlM0VRdWVsJTIwYmlsYW4lMjBhdmFudCUyMGwlRTIlODAlOTlpbnRlcnZlbnRpb24lMjAlM0YlM0MlMkZhJTNFJTNDJTJGbGklM0UlMEElM0NsaSUzRSUzQ2klMjBjbGFzcyUzRCUyMmZhJTIwZmEtY2hldnJvbi1yaWdodCUyMiUzRSUzQyUyRmklM0UlM0NhJTIwaHJlZiUzRCUyMiUyM2NoaXJ1cmdpZSUyMiUzRUNvbW1lbnQlMjBzZSUyMGQlQzMlQTlyb3VsZSUyMGxhJTIwY2hpcnVyZ2llJTIwZHUlMjB0cm91JTIwbWFjdWxhaXJlJTIwJTNGJTNDJTJGYSUzRSUzQyUyRmxpJTNFJTBBJTNDbGklM0UlM0NpJTIwY2xhc3MlM0QlMjJmYSUyMGZhLWNoZXZyb24tcmlnaHQlMjIlM0UlM0MlMkZpJTNFJTNDYSUyMGhyZWYlM0QlMjIlMjNzdWl0ZXMlMjIlM0VRdWVsbGVzJTIwc29udCUyMGxlcyUyMHN1aXRlcyUyMGhhYml0dWVsbGVzJTIwZGUlMjBsJUUyJTgwJTk5aW50ZXJ2ZW50aW9uJTIwJTNGJTNDJTJGYSUzRSUzQyUyRmxpJTNFJTBBJTNDbGklM0UlM0NpJTIwY2xhc3MlM0QlMjJmYSUyMGZhLWNoZXZyb24tcmlnaHQlMjIlM0UlM0MlMkZpJTNFJTNDYSUyMGhyZWYlM0QlMjIlMjNjb21wbGljYXRpb25zJTIyJTNFRWZmZXRzJTIwaW5kJUMzJUE5c2lyYWJsZXMlMjBldCUyMGNvbXBsaWNhdGlvbnMlMjBwb3RlbnRpZWxsZXMlM0MlMkZhJTNFJTNDJTJGbGklM0UlMEElM0MlMkZ1bCUzRQ==
Présentation
JTNDcCUyMGNsYXNzJTNEJTIyZXF1aXBlcyUyMiUzRVVuJTIwdHJvdSUyMG1hY3VsYWlyZSUyMGNvcnJlc3BvbmQlMjAlQzMlQTAlMjB1bmUlMjBpbnRlcnJ1cHRpb24lMjBkZSUyMGxhJTIwciVDMyVBOXRpbmUlMjBlbiUyMHNvbiUyMGNlbnRyZSUyMCUyOG1hY3VsYSUyOS4lM0MlMkZwJTNFJTBBJTNDYnIlMkYlM0UlMEElM0NwJTIwY2xhc3MlM0QlMjJlcXVpcGVzJTIyJTNFRGFucyUyMGxhJTIwbWFqb3JpdCVDMyVBOSUyMGRlcyUyMGNhcyUyQyUyMGwlRTIlODAlOTlhcHBhcml0aW9uJTIwZCVFMiU4MCU5OXVuJTIwdHJvdSUyMG1hY3VsYWlyZSUyMGVzdCUyMGxpJUMzJUE5ZSUyMCVDMyVBMCUyMGwlRTIlODAlOTlleGlzdGVuY2UlMjBkJUUyJTgwJTk5dW5lJTIwYWRoJUMzJUE5cmVuY2UlMjBhbm9ybWFsZSUyMGVudHJlJTIwbGUlMjB2aXRyJUMzJUE5JTIwJTI4aHlhbG8lQzMlQUZkZSUyOSUyMGV0JTIwbGElMjByJUMzJUE5dGluZS4lMjAlM0MlMkZwJTNFJTBBJTNDYnIlMkYlM0UlMEElM0NwJTIwY2xhc3MlM0QlMjJlcXVpcGVzJTIyJTNFQWluc2klMkMlMjBpbCUyMGV4aXN0ZSUyMHBsdXNpZXVycyUyMHN0YWRlcyUyMGQlRTIlODAlOTklQzMlQTl2b2x1dGlvbiUyMHZlcnMlMjB1biUyMHRyb3UlMjBtYWN1bGFpcmUlMkMlMjBzZWxvbiUyMHF1ZSUyMGxhJTIwdHJhY3Rpb24lMjBleGVyYyVDMyVBOWUlMjBzdXIlMjBsYSUyMHIlQzMlQTl0aW5lJTIwZXN0JTIwZCVDMyVBOWJ1dGFudGUlMjBvdSUyMGF2YW5jJUMzJUE5ZS4lM0MlMkZwJTNFJTBBJTNDYnIlMkYlM0UlMEElM0NwJTIwY2xhc3MlM0QlMjJlcXVpcGVzJTIyJTNFVW4lMjB0cm91JTIwbWFjdWxhaXJlJTIwc2UlMjBkJUMzJUE5dmVsb3BwZSUyMHBsdXMlMjBmciVDMyVBOXF1ZW1tZW50JTIwYXByJUMzJUE4cyUyMDY1JTIwYW5zJTJDJTIwZXQlMjB0b3VjaGUlMjBkYXZhbnRhZ2UlMjBsZXMlMjBmZW1tZXMlMjBxdWUlMjBsZXMlMjBob21tZXMuJTNDJTJGcCUzRSUwQSUzQ2JyJTJGJTNFJTBBJTNDcCUyMGNsYXNzJTNEJTIyYXZhbnQtdWwlMjIlM0VVbiUyMHRyb3UlMjBtYWN1bGFpcmUlMjBwZXV0JTIwZW50cmElQzMlQUVuZXIlMjBsZXMlMjBzeW1wdCVDMyVCNG1lcyUyMHN1aXZhbnRzJTIwJTNBJTNDJTJGcCUzRSUwQSUzQ3VsJTNFJTBBJTNDbGklM0VVbmUlMjBiYWlzc2UlMjBkZSUyMGwlRTIlODAlOTlhY3VpdCVDMyVBOSUyMHZpc3VlbGxlJTIwZGUlMjBsb2luJTIwZXQlMkZvdSUyMGRlJTIwcHIlQzMlQThzJTNDJTJGbGklM0UlMEElM0NsaSUzRVVuZSUyMHQlQzMlQTJjaGUlMjBvdSUyMGF1JTIwY29udHJhaXJlJTIwdW4lMjB0cm91JTIwZGFucyUyMGxlJTIwY2hhbXAlMjBkZSUyMHZpc2lvbiUyMC0lMjB1bmUlMjBkJUMzJUE5Zm9ybWF0aW9uJTIwZGVzJTIwaW1hZ2VzJTIwJTI4bGVzJTIwbGlnbmVzJTIwZHJvaXRlcyUyMGFwcGFyYWlzc2VudCUyMGFsb3JzJTIwb25kdWwlQzMlQTllcyUyOSUzQyUyRmxpJTNFJTBBJTNDJTJGdWwlM0UlMEElM0NiciUyRiUzRSUwQSUzQ3AlMjBjbGFzcyUzRCUyMmVxdWlwZXMlMjIlM0VMZSUyMGRpYWdub3N0aWMlMjBkZSUyMHRyb3UlMjBtYWN1bGFpcmUlMjByZXBvc2UlMjBzdXIlMjBsJUUyJTgwJTk5ZXhhbWVuJTIwZHUlMjBmb25kJTIwZCVFMiU4MCU5OSVDNSU5M2lsLiUyME9uJTIwcGV1dCUyMGFsb3JzJTIwb2JzZXJ2ZXIlMjBhdSUyMGNlbnRyZSUyMGRlJTIwbGElMjByJUMzJUE5dGluZSUyMHVuZSUyMG91dmVydHVyZSUyMHJvbmRlJTIwJUMzJUEwJTIwYm9yZHMlMjBuZXRzJTJDJTIwcGx1cyUyMG91JTIwbW9pbnMlMjBhY2NvbXBhZ24lQzMlQTllJTIwZCVFMiU4MCU5OXVuZSUyMG1lbWJyYW5lJTIwcmVjb3V2cmFudCUyMGxhJTIwciVDMyVBOXRpbmUlMjBjZW50cmFsZS4lMEFMZSUyMGRpYWdub3N0aWMlMjBlc3QlMjBwciVDMyVBOWNpcyVDMyVBOSUyMHBhciUyMGwlRTIlODAlOTlPQ1QlMkMlMjBxdWklMjBwZXJtZXQlMjBkZSUyMHZpc3VhbGlzZXIlMjBsZSUyMHRyb3UlMjBtYWN1bGFpcmUlMjBxdWklMjAlMjBhcHBhcmElQzMlQUV0JTIwYWxvcnMlMjBjb21tZSUyMHVuZSUyMGludGVycnVwdGlvbiUyMGNvbXBsJUMzJUE4dGUlMjBvdSUyMG5vbiUyMGRlJTIwbGElMjByJUMzJUE5dGluZSUyMGNlbnRyYWxlLiUzQyUyRnAlM0UlMEElM0NiciUyRiUzRSUwQSUzQ3AlMjBjbGFzcyUzRCUyMmVxdWlwZXMlMjIlM0VMZSUyMHRyYWl0ZW1lbnQlMjBkdSUyMHRyb3UlMjBtYWN1bGFpcmUlMjBlc3QlMjBjaGlydXJnaWNhbC4lMjBJbCUyMGNvbnNpc3RlJTIwZW4lMjB1bmUlMjB2aXRyZWN0b21pZSUyMGF2ZWMlMjBwZWxhZ2UlMjBkZSUyMG1lbWJyYW5lJTIwbGltaXRhbnRlJTIwaW50ZXJuZSUyMGV0JTIwaW5qZWN0aW9uJTIwZGUlMjBnYXouJTIwVW4lMjBwb3NpdGlvbm5lbWVudCUyMGR1JTIwcGF0aWVudCUyMHQlQzMlQUF0ZSUyMHBlbmNoJUMzJUE5ZSUyMGVuJTIwYXZhbnQlMjBkb2l0JTIwJUMzJUFBdHJlJTIwcmVzcGVjdCVDMyVBOSUyMGpvdXIlMjBldCUyMG51aXQlMjBwZW5kYW50JTIwcXVlbHF1ZXMlMjBqb3Vycy4lMjBBaW5zaSUyQyUyMGxlJTIwZ2F6JTIwYXBwdWllJTIwc3VyJTIwbCUyN2FycmklQzMlQThyZSUyMGRlJTIwbCUyNyVDNSU5M2lsJTIwbyVDMyVCOSUyMHNlJTIwdHJvdXZlJTIwbGUlMjB0cm91JTJDJTIwcGVybWV0dGFudCUyMGFpbnNpJTIwc2ElMjBmZXJtZXR1cmUuJTNDJTJGcCUzRQ==
Quand opérer un trou maculaire ?
JTNDcCUyMGNsYXNzJTNEJTIycGFyYWclMjIlM0VMJUUyJTgwJTk5aW50ZXJ2ZW50aW9uJTIwY2hpcnVyZ2ljYWxlJTIwZXN0JTIwZyVDMyVBOW4lQzMlQTlyYWxlbWVudCUyMHByb3BvcyVDMyVBOWUlMjBkJUMzJUE4cyUyMGxvcnMlMjBxdSVFMiU4MCU5OWlsJTIwZXhpc3RlJTIwdW4lMjB0cm91JTIwbWFjdWxhaXJlJTJDJTIwY2FyJTIwY2VsdWktY2klMjBlbnRyYSVDMyVBRW5lJTIwbGUlMjBwbHVzJTIwc291dmVudCUyMHVuZSUyMGclQzMlQUFuZSUyMHZpc3VlbGxlJTIwcmVzc2VudGllJTIwcGFyJTIwbGUlMjBwYXRpZW50LiUyMERlJTIwcGx1cyUyQyUyMHVuJTIwdHJvdSUyMG1hY3VsYWlyZSUyMGElMjB0ZW5kYW5jZSUyMCVDMyVBMCUyMGF1Z21lbnRlciUyMGVuJTIwdGFpbGxlJTIwYXUlMjBjb3VycyUyMGR1JTIwdGVtcHMuJTNDJTJGcCUzRQ==
Quel bilan avant l’intervention ?
JTNDaDMlM0VDb25zdWx0YXRpb24lMjBwciVDMyVBOS1vcCVDMyVBOXJhdG9pcmUlMjBhdmVjJTIwbGUlMjBjaGlydXJnaWVuJTNDJTJGaDMlM0UlMEElM0NwJTIwY2xhc3MlM0QlMjJwYXJhZyUyMiUzRSUzRSUyMEVuJTIwcHJpbmNpcGUlMjBhdSUyMG1vaW5zJTIwOCUyMGpvdXJzJTIwYXZhbnQlMjBsJUUyJTgwJTk5b3AlQzMlQTlyYXRpb24uJTNDYnIlMkYlM0UlMEElM0UlMjBDZXR0ZSUyMGNvbnN1bHRhdGlvbiUyMGNvbXBvcnRlJTIwdW5lJTIwbWVzdXJlJTIwZGUlMjBsYSUyMHZpc2lvbiUyMGV0JTIwdW4lMjBleGFtZW4lMjBhdmVjJTIwZGlsYXRhdGlvbiUyMGRlJTIwbGElMjBwdXBpbGxlLiUyMExlJTIwY2hpcnVyZ2llbiUyMGRvbm5lJTIwbGVzJTIwZXhwbGljYXRpb25zJTIwbiVDMyVBOWNlc3NhaXJlcyUyQyUyMGV0JTIwciVDMyVBOXBvbmQlMjBhdXglMjBxdWVzdGlvbnMlMjBkdSUyMHBhdGllbnQuJTNDJTJGcCUzRSUwQSUwQSUzQ2gzJTNFRXhhbWVucyUyMGNvbXBsJUMzJUE5bWVudGFpcmVzJTIwcHIlQzMlQTktb3AlQzMlQTlyYXRvaXJlcyUyMGhhYml0dWVscyUyMCUzQyUyRmgzJTNFJTBBJTNDcCUyMGNsYXNzJTNEJTIycGFyYWclMjIlM0UlM0UlMjBPQ1QlMjBkZSUyMGxhJTIwciVDMyVBOXRpbmUlMjBldCUyMGR1JTIwbmVyZiUyMG9wdGlxdWUuJTNDYnIlMkYlM0UlMEElM0UlMjBSJUMzJUE5dGlub2dyYXBoaWUlMjBjb3VsZXVyJTIwJUMzJUE5dmFsdWFudCUyMGwlRTIlODAlOTklQzMlQTl0YXQlMjBkZSUyMGxhJTIwciVDMyVBOXRpbmUlMjBldCUyMGR1JTIwbmVyZiUyMG9wdGlxdWUuJTNDJTJGcCUzRSUwQSUwQSUzQ2gzJTNFQ29uc3VsdGF0aW9uJTIwYW5lc3RoJUMzJUE5c2lxdWUlMjAlM0MlMkZoMyUzRSUwQSUzQ3AlMjBjbGFzcyUzRCUyMnBhcmFnJTIyJTNFJTNFJTIwRWxsZSUyMGVzdCUyMG9ibGlnYXRvaXJlJTIwZW4lMjBjYXMlMjBkJUUyJTgwJTk5aG9zcGl0YWxpc2F0aW9uJTIwY2xhc3NpcXVlJTIwb3UlMjBhbWJ1bGF0b2lyZS4lM0NiciUyRiUzRSUwQSUzRSUyMEVsbGUlMjBlc3QlMjByJUMzJUE5YWxpcyVDMyVBOWUlMjBwYXIlMjBsJUUyJTgwJTk5YW5lc3RoJUMzJUE5c2lzdGUlMjBkZSUyMGxhJTIwY2xpbmlxdWUlMjBhdSUyMG1pbmltdW0lMjAzJTIwam91cnMlMjBhdmFudCUyMGwlRTIlODAlOTlvcCVDMyVBOXJhdGlvbi4lM0NiciUyRiUzRSUwQSUzRSUyMEVsbGUlMjBmYWl0JTIwbGUlMjBiaWxhbiUyMGRlJTIwbCVFMiU4MCU5OSVDMyVBOXRhdCUyMGclQzMlQTluJUMzJUE5cmFsJTIwZXQlMjBkZXMlMjAlQzMlQTl2ZW50dWVscyUyMGFqdXN0ZW1lbnRzJTIwZHUlMjB0cmFpdGVtZW50JTIwZyVDMyVBOW4lQzMlQTlyYWwlMjAlQzMlQTAlMjBlZmZlY3R1ZXIlMjBhdmFudCUyMGV0JTIwYXByJUMzJUE4cyUyMGwlRTIlODAlOTlpbnRlcnZlbnRpb24lMjAlMjhhbnRpLWFnciVDMyVBOWdhbnRzJTJDJTIwYW50aS1jb2FndWxhbnRzJTJDJTIwYW50aWQlQzMlQTlwcmVzc2V1cnMuLi4lMjkuJTIwJTNDJTJGcCUzRQ==
Comment se déroule la chirurgie du trou maculaire ?
JTNDcCUyMGNsYXNzJTNEJTIycGFyYWclMjIlM0VMYSUyMGNoaXJ1cmdpZSUyMGR1JTIwdHJvdSUyMG1hY3VsYWlyZSUyMHBldXQlMjAlQzMlQUF0cmUlMjBmYWl0ZSUyMGVuJTIwaG9zcGl0YWxpc2F0aW9uJTIwYW1idWxhdG9pcmUlMjBvdSUyMGVuJTIwaG9zcGl0YWxpc2F0aW9uJTIwY2xhc3NpcXVlLiUyMEwlRTIlODAlOTlhbmVzdGglQzMlQTlzaWUlMjBwcmF0aXF1JUMzJUE5ZSUyMHBldXQlMjAlQzMlQUF0cmUlMjBsb2NhbGUlMjBvdSUyMGclQzMlQTluJUMzJUE5cmFsZSUyQyUyMGVuJTIwZm9uY3Rpb24lMjBkZSUyMGwlRTIlODAlOTklQzMlQTl0YXQlMjBnJUMzJUE5biVDMyVBOXJhbCUyMGV0JTIwb2N1bGFpcmUlMjBkdSUyMHBhdGllbnQuJTIwRW4lMjBjYXMlMjBkJUUyJTgwJTk5YW5lc3RoJUMzJUE5c2llJTIwbG9jYWxlJTJDJTIwdW5lJTIwb3UlMjBkZXV4JTIwaW5qZWN0aW9ucyUyMHNvbnQlMjBwcmF0aXF1JUMzJUE5ZXMlMjBhdXRvdXIlMjBkZSUyMGwlRTIlODAlOTklQzUlOTNpbC4lM0NiciUyRiUzRSUzQ2JyJTJGJTNFJTBBTGElMjBkdXIlQzMlQTllJTIwbW95ZW5uZSUyMGQlRTIlODAlOTl1bmUlMjBpbnRlcnZlbnRpb24lMjBlc3QlMjBkZSUyMDFIJTJDJTIwYXZlYyUyMHVuZSUyMHByJUMzJUE5c2VuY2UlMjBkJUUyJTgwJTk5ZW52aXJvbiUyMDFIMzAlMjBlbiUyMHNhbGxlJTIwb3AlQzMlQTlyYXRvaXJlLiUyMCUzQyUyRnAlM0UlMEElMEElM0NoMyUzRUxhJTIwdmVpbGxlJTIwZGUlMjBsJUUyJTgwJTk5b3AlQzMlQTlyYXRpb24lM0MlMkZoMyUzRSUwQSUzQ3AlMjBjbGFzcyUzRCUyMnBhcmFnJTIyJTNFJTNFJTIwTGUlMjBwYXRpZW50JTIwYWNoJUMzJUE4dGUlMjBsZXMlMjBjb2xseXJlcyUyMHByJUMzJUE5JTIwZXQlMjBwb3N0LW9wJUMzJUE5cmF0b2lyZXMlMjAlQzMlQTAlMjBsYSUyMHBoYXJtYWNpZS4lM0NiciUyRiUzRSUwQSUzRSUyMFVuZSUyMGRvdWNoZSUyMCVDMyVBMCUyMGxhJTIwQiVDMyVBOXRhZGluZSUyMGVzdCUyMHIlQzMlQTlhbGlzJUMzJUE5ZSUyMGxhJTIwdmVpbGxlJTIwZXQlMjBsZSUyMG1hdGluJTIwZGUlMjBsJUUyJTgwJTk5aW50ZXJ2ZW50aW9uLiUwQSUzQyUyRnAlM0UlMEElMEElM0NoMyUzRUxlJTIwam91ciUyMGRlJTIwbCVFMiU4MCU5OW9wJUMzJUE5cmF0aW9uJTNDJTJGaDMlM0UlMEElM0NwJTIwY2xhc3MlM0QlMjJwYXJhZyUyMiUzRUxlJTIwcGF0aWVudCUyMGVzdCUyMCVDMyVBMCUyMGplJUMzJUJCbiUyMGRlcHVpcyUyMGF1JTIwbW9pbnMlMjA2SCUyMGF2YW50JTIwbCVFMiU4MCU5OWhldXJlJTIwcHIlQzMlQTl2dWUlMjBkZSUyMGwlRTIlODAlOTlpbnRlcnZlbnRpb24uJTIwMUglMjBhdmFudCUyMGwlRTIlODAlOTlpbnRlcnZlbnRpb24lMkMlMjBsYSUyMHB1cGlsbGUlMjBlc3QlMjBkaWxhdCVDMyVBOWUlMjAlQzMlQTAlMjBsJUUyJTgwJTk5YWlkZSUyMGRlJTIwY29sbHlyZXMuJTIwTGUlMjBwYXRpZW50JTIwZXN0JTIwY29uZHVpdCUyMGVuJTIwc2FsbGUlMjBvcCVDMyVBOXJhdG9pcmUlMjBzdXIlMjB1biUyMGJyYW5jYXJkLiUyMEwlRTIlODAlOTlhbmVzdGglQzMlQTlzaWUlMjBnJUMzJUE5biVDMyVBOXJhbGUlMjBvdSUyMGxvY2FsZSUyMGVzdCUyMGFsb3JzJTIwcHJhdGlxdSVDMyVBOWUuJTIwTGElMjB0JUMzJUFBdGUlMjBlc3QlMjBkJUMzJUE5bGljYXRlbWVudCUyMGZpeCVDMyVBOWUlMjBhdSUyMGJyYW5jYXJkJTIwJUMzJUEwJTIwbCVFMiU4MCU5OWFpZGUlMjBkJUUyJTgwJTk5dW4lMjBzcGFyYWRyYXAuJTIwRW5maW4lMkMlMjBsZSUyMHBhdGllbnQlMjBlc3QlMjByZWNvdXZlcnQlMjBkJUUyJTgwJTk5dW4lMjBkcmFwJTIwc3QlQzMlQTlyaWxlJTIwYXBwZWwlQzMlQTklMjAlQzIlQUIlMjBjaGFtcCUyMG9wJUMzJUE5cmF0b2lyZSUyMCVDMiVCQi4lM0MlMkZwJTNFJTBBJTBBJTNDaDMlM0VMJTI3aW50ZXJ2ZW50aW9uJTJDJTIwJUMzJUE5dGFwZSUyMHBhciUyMCVDMyVBOXRhcGUlM0MlMkZoMyUzRSUwQSUzQ3AlMjBjbGFzcyUzRCUyMnBhcmFnJTIyJTNFTCVFMiU4MCU5OWludGVydmVudGlvbiUyMGNoaXJ1cmdpY2FsZSUyMGVzdCUyMHIlQzMlQTlzdW0lQzMlQTllJTIwc291cyUyMGxlcyUyMHRlcm1lcyUyMCVDMiVBQiUyMHZpdHJlY3RvbWllJTIwJTJCJTIwcGVsYWdlJTIwJTJCJTIwaW5qZWN0aW9uJTIwZGUlMjBnYXolMjAlQzIlQkIuJTNDJTJGcCUzRSUwQSUzQ3AlMjBjbGFzcyUzRCUyMnBhcmFnJTIyJTNFJTNDc3BhbiUyMGNsYXNzJTNEJTIydGl0cmUlMjIlM0UlQzMlODl0YXBlJTIwMSUyMCUzQSUzQyUyRnNwYW4lM0VUcm9pcyUyMHRyb2NhcnRzJTIwJTI4dHViZXMlMjklMjBzb250JTIwZW5jaCVDMyVBMnNzJUMzJUE5cyUyMGF1JTIwbml2ZWF1JTIwZGUlMjBsYSUyMHBhcm9pJTIwb2N1bGFpcmUlMjBwb3VyJTIwcGVybWV0dHJlJTIwbCVFMiU4MCU5OWluc2VydGlvbiUyMGQlRTIlODAlOTlpbnN0cnVtZW50cyUyMGV0JTIwbCVFMiU4MCU5OWluZnVzaW9uJTIwY29udGludWUlMjBkZSUyMGZsdWlkZSUyMGRhbnMlMjAlMjBsJUUyJTgwJTk5JUM1JTkzaWwlMjBwZW5kYW50JTIwbCVFMiU4MCU5OWludGVydmVudGlvbi4lM0MlMkZwJTNFJTBBJTNDcCUyMGNsYXNzJTNEJTIycGFyYWclMjIlM0UlM0NzcGFuJTIwY2xhc3MlM0QlMjJ0aXRyZSUyMiUzRSVDMyU4OXRhcGUlMjAyJTIwJTNBJTIwJTNDJTJGc3BhbiUzRUF1JTIwY291cnMlMjBkZSUyMGNldHRlJTIwcGhhc2UlMjBhcHBlbCVDMyVBOWUlMjB2aXRyZWN0b21pZSUyMHVuZSUyMHNvbmRlJTIwbHVtaW5ldXNlJTIwZXQlMjB1biUyMGluc3RydW1lbnQlMkMlMjBsZSUyMHZpdHIlQzMlQTlvdG9tZSUyQyUyMHNvbnQlMjBpbnMlQzMlQTlyJUMzJUE5cyUyMGRhbnMlMjBsJUUyJTgwJTk5JUM1JTkzaWwlMjBhZmluJTIwZCVFMiU4MCU5OWFzcGlyZXIlMjBtaW51dGlldXNlbWVudCUyMGxlJTIwdml0ciVDMyVBOSUyMCUyOGdlbCUyMHJlbXBsaXNzYW50JTIwbGElMjBjYXZpdCVDMyVBOSUyMG9jdWxhaXJlJTIwZXQlMjBlbXAlQzMlQUFjaGFudCUyMGwlRTIlODAlOTlhY2MlQzMlQThzJTIwJUMzJUEwJTIwbGElMjByJUMzJUE5dGluZSUyOS4lM0MlMkZwJTNFJTBBJTNDcCUyMGNsYXNzJTNEJTIycGFyYWclMjIlM0UlM0NzcGFuJTIwY2xhc3MlM0QlMjJ0aXRyZSUyMiUzRSVDMyU4OXRhcGUlMjAzJTIwJTNBJTIwJTNDJTJGc3BhbiUzRUluamVjdGlvbiUyMGludHJhb2N1bGFpcmUlMjBkJUUyJTgwJTk5dW4lMjBjb2xvcmFudCUyMHNwJUMzJUE5Y2lmaXF1ZSUyMGRlJTIwbGElMjBtZW1icmFuZSUyMGxpbWl0YW50ZSUyMGludGVybmUlMjBkYW5zJTIwbGUlMjBidXQlMjBkJUUyJTgwJTk5YW0lQzMlQTlsaW9yZXIlMjBzYSUyMHZpc3VhbGlzYXRpb24lM0MlMkZwJTNFJTBBJTNDcCUyMGNsYXNzJTNEJTIycGFyYWclMjIlM0UlM0NzcGFuJTIwY2xhc3MlM0QlMjJ0aXRyZSUyMiUzRSVDMyU4OXRhcGUlMjA0JTIwJTNBJTIwJTNDJTJGc3BhbiUzRVBlbGFnZSUyMG1pbnV0aWV1eCUyMGRlJTIwbGElMjBtZW1icmFuZSUyMGxpbWl0YW50ZSUyMGludGVybmUlMjAlQzMlQTAlMjBsJUUyJTgwJTk5YWlkZSUyMGQlRTIlODAlOTl1bmUlMjBwaW5jZSUyMHNwJUMzJUE5Y2lmaXF1ZS4lM0MlMkZwJTNFJTBBJTNDcCUyMGNsYXNzJTNEJTIycGFyYWclMjIlM0UlM0NzcGFuJTIwY2xhc3MlM0QlMjJ0aXRyZSUyMiUzRSVDMyU4OXRhcGUlMjA1JTIwJTNBJTIwJTNDJTJGc3BhbiUzRSVDMyU4OWNoYW5nZSUyMGR1JTIwZmx1aWRlJTIwJUMzJUEwJTIwbCVFMiU4MCU5OWludCVDMyVBOXJpZXVyJTIwZGUlMjBsJUUyJTgwJTk5JUM1JTkzaWwlMjBwYXIlMjBkZSUyMGwlRTIlODAlOTlhaXIlMjBzdCVDMyVBOXJpbGUlMkMlMjBwdWlzJTIwZHUlMjBnYXouJTNDJTJGcCUzRSUwQSUzQ3AlMjBjbGFzcyUzRCUyMnBhcmFnJTIyJTNFJTNDc3BhbiUyMGNsYXNzJTNEJTIydGl0cmUlMjIlM0UlQzMlODl0YXBlJTIwNiUyMCUzQSUyMCUzQyUyRnNwYW4lM0VWJUMzJUE5cmlmaWNhdGlvbiUyMGRlJTIwbCVFMiU4MCU5OWFic2VuY2UlMjBkJUUyJTgwJTk5YXV0cmUlMjBsJUMzJUE5c2lvbi4lM0MlMkZwJTNFJTBBJTNDcCUyMGNsYXNzJTNEJTIycGFyYWclMjIlM0UlM0NzcGFuJTIwY2xhc3MlM0QlMjJ0aXRyZSUyMiUzRSVDMyU4OXRhcGUlMjA3JTIwJTNBJTIwJTNDJTJGc3BhbiUzRUFibGF0aW9uJTIwZGVzJTIwdHJvY2FydHMlMjBldCUyMHN1dHVyZSUyMGRlcyUyMG9yaWZpY2VzLiUzQyUyRnAlM0UlMEElMEElMEElM0NoMyUzRUFwciVDMyVBOHMlMjBsJTI3aW50ZXJ2ZW50aW9uJTNDJTJGaDMlM0UlMEElM0NwJTNFQXByJUMzJUE4cyUyMGwlRTIlODAlOTlpbnRlcnZlbnRpb24lMkMlMjBsZSUyMHBhdGllbnQlMjBlc3QlMjBjb25kdWl0JTIwZW4lMjBzYWxsZSUyMGRlJTIwc3VydmVpbGxhbmNlJTIwcG9zdC1pbnRlcnZlbnRpb25uZWxsZS4lMjBJbCUyMGVzdCUyMGVuc3VpdGUlMjBjb25kdWl0JTIwZGFucyUyMHNhJTIwY2hhbWJyZSUyMG91JTIwcmVudHJlJTIwJUMzJUEwJTIwc29uJTIwZG9taWNpbGUlMjBhcHIlQzMlQThzJTIwcXVlbHF1ZXMlMjBoZXVyZXMlMjBkZSUyMHN1cnZlaWxsYW5jZS4lMEElMEFBdSUyMGNvdXJzJTIwZGUlMjBsJUUyJTgwJTk5aW50ZXJ2ZW50aW9uJTJDJTIwbGUlMjBmbHVpZGUlMjBwciVDMyVBOXNlbnQlMjBkYW5zJTIwbGElMjBjYXZpdCVDMyVBOSUyMG9jdWxhaXJlJTIwYSUyMCVDMyVBOXQlQzMlQTklMjByZW1wbGFjJUMzJUE5JTIwcGFyJTIwZHUlMjBnYXouJTIwTGUlMjBnYXolMjBpbnRyYW9jdWxhaXJlJTIwc2UlMjByJUMzJUE5c29yYmUlMjBzcG9udGFuJUMzJUE5bWVudCUyMGV0JTIwcHJvZ3Jlc3NpdmVtZW50JTIwZW4lMjAyJTIwc2VtYWluZXMlMjAlQzMlQTAlMjAyJTIwbW9pcy4lMjAlMEElM0MlMkZwJTNFJTBBJTBBJTNDcCUyMGNsYXNzJTNEJTIyYXZhbnQtdWwlMjIlM0VMZXMlMjBjb25zJUMzJUE5cXVlbmNlcyUyMGRlJTIwbGElMjBwciVDMyVBOXNlbmNlJTIwZGUlMjBnYXolMjBpbnRyYW9jdWxhaXJlJTIwc29udCUyMGxlcyUyMHN1aXZhbnRlcyUyMCUzQSUzQyUyRnAlM0UlMEElM0N1bCUzRSUwQSUzQ2xpJTNFJTNDc3Ryb25nJTNFVmlzaW9uJTIwdHIlQzMlQThzJTIwZmxvdWUlM0MlMkZzdHJvbmclM0UlMjBwZW5kYW50JTIwcXVlbHF1ZXMlMjBzZW1haW5lcyUyQyUyMHB1aXMlMjB2aXN1YWxpc2F0aW9uJTIwZCVFMiU4MCU5OXVuZSUyMCUzQ3N0cm9uZyUzRWJ1bGxlJTIwbW9iaWxlJTNDJTJGc3Ryb25nJTNFJTIwZGFucyUyMGxhJTIwcGFydGllJTIwaW5mJUMzJUE5cmlldXJlJTIwZHUlMjBjaGFtcCUyMHZpc3VlbCUyMHBlbmRhbnQlMjBxdWVscXVlcyUyMHNlbWFpbmVzJTIwJTNCJTIwY2VzJTIwc3ltcHQlQzMlQjRtZXMlMjBkaXNwYXJhaXNzZW50JTIwbG9yc3F1ZSUyMGxlJTIwZ2F6JTIwYSUyMHRvdGFsZW1lbnQlMjBkaXNwYXJ1JTNDJTJGbGklM0UlMEElM0NsaSUzRSUzQ3N0cm9uZyUzRUludGVyZGljdGlvbiUyMGFic29sdWUlMjBkZSUyMHByZW5kcmUlMjBsJUUyJTgwJTk5YXZpb24lM0MlMkZzdHJvbmclM0UlMjBvdSUyMGRlJTIwdm95YWdlciUyMCVDMyVBMCUyMHBsdXMlMjBkZSUyMDEwMDAlMjBtJUMzJUE4dHJlcyUyMGQlRTIlODAlOTlhbHRpdHVkZSUzQyUyRmxpJTNFJTBBJTNDbGklM0VFbiUyMGNhcyUyMGQlMjdhbmVzdGglQzMlQTlzaWUlMjBnJUMzJUE5biVDMyVBOXJhbGUlMjBwb3VyJTIwdW4lMjBhdXRyZSUyMG1vdGlmJTJDJTIwbGElMjBwciVDMyVBOXNlbmNlJTIwZGUlMjBnYXolMjBpbnRyYW9jdWxhaXJlJTIwZG9pdCUyMCVDMyVBQXRyZSUyMCUzQ3N0cm9uZyUzRXNpZ25hbCVDMyVBOWUlMjAlQzMlQTAlMjBsJTI3YW5lc3RoJUMzJUE5c2lzdGUlM0MlMkZzdHJvbmclM0UlM0MlMkZsaSUzRSUwQSUzQ2xpJTNFTWFqb3JhdGlvbiUyMGR1JTIwJTNDc3Ryb25nJTNFcmlzcXVlJTIwZGUlMjBjYXRhcmFjdGUlM0MlMkZzdHJvbmclM0UlM0MlMkZsaSUzRSUwQSUzQyUyRnVsJTNFJTNDcCUzRUxlJTIwcG9zaXRpb25uZW1lbnQlMjBwb3N0LW9wJUMzJUE5cmF0b2lyZSUyMCVDMiVBQiUyMGZhY2UlMjB2ZXJzJTIwbGUlMjBzb2wlMjAlQzIlQkIlMjBlc3QlMjBkJUMzJUE5YnV0JUMzJUE5JTIwbGUlMjBwbHVzJTIwdCVDMyVCNHQlMjBwb3NzaWJsZSUyQyUyMGV0JTIwZG9pdCUyMCVDMyVBQXRyZSUyMHJlc3BlY3QlQzMlQTklMjBqb3VyJTIwZXQlMjBudWl0JTIwcGVuZGFudCUyMHF1ZWxxdWVzJTIwam91cnMuJTIwQWluc2klMkMlMjBsZSUyMGdheiUyMGFwcHVpZSUyMHN1ciUyMGwlMjdhcnJpJUMzJUE4cmUlMjBkZSUyMGwlMjclQzUlOTNpbCUyMG8lQzMlQjklMjBzZSUyMHRyb3V2ZSUyMGxlJTIwdHJvdSUyQyUyMGV0JTIwc2VzJTIwY2hhbmNlcyUyMGRlJTIwZmVybWV0dXJlJTIwc29udCUyMGF1Z21lbnQlQzMlQTllcy4lM0MlMkZwJTNFJTBBJTNDYnIlMkYlM0UlMEElM0NwJTNFTGUlMjBsZW5kZW1haW4lMjBtYXRpbiUyMGRlJTIwbCVFMiU4MCU5OWludGVydmVudGlvbiUyQyUyMGxhJTIwY29xdWUlMjBkZSUyMHByb3RlY3Rpb24lMjBlc3QlMjByZXRpciVDMyVBOWUlMkMlMjBldCUyMGxlJTIwdHJhaXRlbWVudCUyMHBvc3Qtb3AlQzMlQTlyYXRvaXJlJTIwZXN0JTIwZCVDMyVBOWJ1dCVDMyVBOSUyMHBvdXIlMjB1bmUlMjBkdXIlQzMlQTllJTIwZGUlMjAxJTIwbW9pcy4lMEFMYSUyMGNvcXVlJTIwZGUlMjBwcm90ZWN0aW9uJTIwZG9pdCUyMCVDMyVBQXRyZSUyMGZpeCVDMyVBOWUlMjBzdXIlMjBsJUUyJTgwJTk5JUM1JTkzaWwlMjBhdSUyMHNwYXJhZHJhcCUyMGxlcyUyMDclMjBwcmVtaSVDMyVBOHJlcyUyMG51aXRzJTIwYWZpbiUyMGQlRTIlODAlOTklQzMlQTl2aXRlciUyMGxlJTIwZnJvdHRlbWVudCUyMGRlJTIwbCVFMiU4MCU5OSVDNSU5M2lsLiUyMEVuJTIwam91cm4lQzMlQTllJTJDJTIwYXVjdW4lMjBwYW5zZW1lbnQlMjBuJUUyJTgwJTk5ZXN0JTIwbiVDMyVBOWNlc3NhaXJlLiUzQyUyRnAlM0UlMEElM0NiciUyRiUzRSUwQSUzQ3AlM0VVbiUyMGNvbnRyJUMzJUI0bGUlMjBwb3N0LW9wJUMzJUE5cmF0b2lyZSUyMGVzdCUyMGltcCVDMyVBOXJhdGlmJTIwYXUlMjBjb3VycyUyMGRlcyUyMGpvdXJzJTIwc3VpdmFudCUyMGwlRTIlODAlOTlpbnRlcnZlbnRpb24uJTNDJTJGcCUzRSUwQSUzQ2JyJTJGJTNFJTBBJTNDcCUzRVVuJTIwbW9pcyUyMGFwciVDMyVBOHMlMjBsJUUyJTgwJTk5aW50ZXJ2ZW50aW9uJTJDJTIwdW5lJTIwY29uc3VsdGF0aW9uJTIwYXZlYyUyMGxlJTIwY2hpcnVyZ2llbiUyMHBlcm1ldCUyMGRlJTIwY29udHIlQzMlQjRsZXIlMjBsZSUyMHIlQzMlQTlzdWx0YXQlMjBkZSUyMGwlRTIlODAlOTlvcCVDMyVBOXJhdGlvbi4lM0MlMkZwJTNF
Quelles sont les suites habituelles de l’intervention ?
JTNDaDMlM0VTdWl0ZXMlMjAlQzMlQTAlMjBjb3VydCUyMHRlcm1lJTNDJTJGaDMlM0UlMEElM0NwJTIwY2xhc3MlM0QlMjJwYXJhZyUyMiUzRUwlMjclQzUlOTNpbCUyMG9wJUMzJUE5ciVDMyVBOSUyMGRlJTIwdHJvdSUyMG1hY3VsYWlyZSUyMGVzdCUyMGclQzMlQTluJUMzJUE5cmFsZW1lbnQlMjBpbmRvbG9yZS4lMjBDZXBlbmRhbnQlMkMlMjB1bmUlMjBnJUMzJUFBbmUlMjBvdSUyMHVuZSUyMGRvdWxldXIlMjBtb2QlQzMlQTlyJUMzJUE5ZXMlMjBzb250JTIwcG9zc2libGVzJTIwYXByJUMzJUE4cyUyMGwlRTIlODAlOTlpbnRlcnZlbnRpb24lMjBldCUyMGRvaXZlbnQlMjBwYXNzZXIlMjBlbiUyMHF1ZWxxdWVzJTIwam91cnMuJTNDJTJGcCUzRSUwQSUzQ3AlMjBjbGFzcyUzRCUyMnBhcmFnJTIyJTNFVW4lMjB0cmFpdGVtZW50JTIwY29udHJlJTIwbGElMjBkb3VsZXVyJTIwcGV1dCUyMCVDMyVBQXRyZSUyMGRvbm4lQzMlQTklMkMlMjBkZSUyMHR5cGUlMjBQYXJhYyVDMyVBOXRhbW9sJTNDJTJGcCUzRSUwQSUzQ3AlMjBjbGFzcyUzRCUyMnBhcmFnJTIyJTNFTGVzJTIwc29pbnMlMjBsb2NhdXglMjBzb250JTIwciVDMyVBOWR1aXRzJTIwJUMzJUEwJTIwbCUyN2luc3RpbGxhdGlvbiUyMGRlJTIwZ291dHRlcyUyMGV0JTIwZGUlMjBwb21tYWRlJTIwcGVuZGFudCUyMDQlMjBzZW1haW5lcyUyQyUyMGV0JTIwYXUlMjBwb3J0JTIwZCUyN3VuZSUyMHByb3RlY3Rpb24lMjBvY3VsYWlyZSUyMHBlbmRhbnQlMjBsZXMlMjA3JTIwcHJlbWklQzMlQThyZXMlMjBudWl0cy4lM0MlMkZwJTNFJTBBJTNDcCUyMGNsYXNzJTNEJTIycGFyYWclMjIlM0VTaSUyMGRlcyUyMHN1dHVyZXMlMjBvbnQlMjAlQzMlQTl0JUMzJUE5JTIwcG9zJUMzJUE5ZXMlMkMlMjBlbGxlcyUyMHNvbnQlMjByJUMzJUE5c29yYmFibGVzJTIwZXQlMjBkaXNwYXJhJUMzJUFFdHJvbnQlMjBzcG9udGFuJUMzJUE5bWVudCUyMGRhbnMlMjBsZXMlMjBzZW1haW5lcyUyMHN1aXZhbnQlMjBsJUUyJTgwJTk5b3AlQzMlQTlyYXRpb24uJTNDJTJGcCUzRSUwQSUzQ3AlMjBjbGFzcyUzRCUyMiUyMmF2YW50LXVsJTNFTGElMjBwZXJjZXB0aW9uJTIwaW5pdGlhbGUlMjBkZXMlMjBwaCVDMyVBOW5vbSVDMyVBOG5lcyUyMHN1aXZhbnRzJTIwZXN0JTIwbm9ybWFsZSUyMCUzQSUyMCUzQyUyRnAlM0UlMEElM0N1bCUzRSUwQSUzQ2xpJTNFVmlzaW9uJTIwdHIlQzMlQThzJTIwZmxvdWUlMjBsZXMlMjBwcmVtaSVDMyVBOHJlcyUyMHNlbWFpbmVzJTNDJTJGbGklM0UlMEElM0NsaSUzRUxhcm1vaWVtZW50JTJDJTIwcGljb3RlbWVudHMlM0MlMkZsaSUzRSUwQSUzQ2xpJTNFU2Vuc2liaWxpdCVDMyVBOSUyMGFjY3J1ZSUyMCVDMyVBMCUyMGxhJTIwbHVtaSVDMyVBOHJlJTNDJTJGbGklM0UlMEElM0MlMkZ1bCUzRSUwQSUzQ3AlM0VUciVDMyVBOHMlMjByYXJlbWVudCUyQyUyMGxhJTIwJTNDc3Ryb25nJTNFZCVDMyVBOWNvdXZlcnRlJTIwZCUyN2F1dHJlcyUyMGwlQzMlQTlzaW9ucyUyMGRlJTIwbCUyNyVDNSU5M2lsJTIwcGV1dCUyMGxpbWl0ZXIlMjBsYSUyMHIlQzMlQTljdXAlQzMlQTlyYXRpb24lMjB2aXN1ZWxsZS4lMjAlM0MlMkZzdHJvbmclM0UlMEElM0NiciUyRiUzRSUzQ2JyJTJGJTNFJTBBVW4lMjBhcnIlQzMlQUF0JTIwZGUlMjB0cmF2YWlsJTIwZXN0JTIwbGUlMjBwbHVzJTIwc291dmVudCUyMHByZXNjcml0JTIwbGVzJTIwcHJlbWklQzMlQThyZXMlMjBzZW1haW5lcy4lMjBMYSUyMGNvbmR1aXRlJTIwYXV0b21vYmlsZSUyMGVzdCUyMGxlJTIwcGx1cyUyMHNvdXZlbnQlMjBwb3NzaWJsZSUyMGQlQzMlQThzJTIwcXVlJTIwbGUlMjBzdWpldCUyMHMlRTIlODAlOTllbiUyMHNlbnQlMjBjYXBhYmxlLiUyMExlcyUyMHNwb3J0cyUyMG5vbiUyMHZpb2xlbnRzJTIwc29udCUyMGF1dG9yaXMlQzMlQTlzJTIwdW4lMjBtb2lzJTIwYXByJUMzJUE4cyUyMGxhJTIwY2hpcnVyZ2llLiUyMExlcyUyMGJhaW5zJTIwYXZlYyUyMGltbWVyc2lvbiUyMGRlJTIwbCVFMiU4MCU5OSVDNSU5M2lsJTIwc29udCUyMGludGVyZGl0cyUyMHBlbmRhbnQlMjAxNSUyMGpvdXJzLiUyMExhJTIwZG91Y2hlJTIwZXN0JTIwcG9zc2libGUlMjBkJUMzJUE4cyUyMGxlJTIwbGVuZGVtYWluJTIwZW4lMjBwcmVuYW50JTIwc29pbiUyMGRlJTIwbmUlMjBwYXMlMjBmYWlyZSUyMHJ1aXNzZWxlciUyMGwlRTIlODAlOTllYXUlMjBkdSUyMHJvYmluZXQlMjBkYW5zJTIwbCVFMiU4MCU5OSVDNSU5M2lsJTIwb3AlQzMlQTlyJUMzJUE5LiUyMExlJTIwcG9ydCUyMGRlJTIwbHVuZXR0ZXMlMjBkZSUyMHNvbGVpbCUyMGVzdCUyMGNvbnNlaWxsJUMzJUE5JTIwY29tbWUlMjBwb3VyJTIwdG91dGUlMjBwZXJzb25uZSUyMG5vcm1hbGUlMjBlbiUyMGNhcyUyMGRlJTIwc29sZWlsJTIwb3UlMjBkZSUyMGclQzMlQUFuZSUyMCVDMyVBMCUyMGxhJTIwZm9ydGUlMjBsdW1pbm9zaXQlQzMlQTkuJTIwJTNDJTJGcCUzRSUwQSUwQSUzQ2gzJTNFU3VpdGVzJTIwJUMzJUEwJTIwbG9uZyUyMHRlcm1lJTNDJTJGaDMlM0UlMEElM0NwJTIwY2xhc3MlM0QlMjJwYXJhZyUyMiUzRUxhJTIwY2hpcnVyZ2llJTIwcGVybWV0JTIwZCVFMiU4MCU5OW9idGVuaXIlMjBsYSUyMGZlcm1ldHVyZSUyMGR1JTIwdHJvdSUyMG1hY3VsYWlyZSUyMGRhbnMlMjBsYSUyMG1ham9yaXQlQzMlQTklMjBkZXMlMjBjYXMlMkMlMjBhdmVjJTIwdW4lMjB0YXV4JTIwZGUlMjBmZXJtZXR1cmUlMjBkJUMzJUE5cGFzc2FudCUyMDkwJTIwJTI1JTIwcG91ciUyMGxlcyUyMHRyb3VzJTIwZGUlMjBwZXRpdGUlMjB0YWlsbGUuJTIwJTNDJTJGcCUzRSUwQSUwQSUzQ3AlMjBjbGFzcyUzRCUyMnBhcmFnJTIyJTNFTCVFMiU4MCU5OWFtJUMzJUE5bGlvcmF0aW9uJTIwZGVzJTIwc3ltcHQlQzMlQjRtZXMlMjBuJUUyJTgwJTk5ZXN0JTIwJTNDc3Ryb25nJTNFcGFzJTIwaW1tJUMzJUE5ZGlhdGUlM0MlMkZzdHJvbmclM0UlMkMlMjBldCUyMGElMjBsaWV1JTIwJTNDc3Ryb25nJTNFcHJvZ3Jlc3NpdmVtZW50JTIwYXUlMjBjb3VycyUyMGRlcyUyMHNlbWFpbmVzJTNDJTJGc3Ryb25nJTNFJTIwc3VpdmFudCUyMGwlRTIlODAlOTlpbnRlcnZlbnRpb24lMjBjaGlydXJnaWNhbGUlMkMlMjAlM0NzdHJvbmclM0VhcHIlQzMlQThzJTIwciVDMyVBOXNvcnB0aW9uJTIwZHUlMjBnYXolMjBpbnRyYW9jdWxhaXJlLiUzQyUyRnN0cm9uZyUzRSUzQyUyRnAlM0UlMEElMEElM0NwJTIwY2xhc3MlM0QlMjJwYXJhZyUyMiUzRUwlRTIlODAlOTlhbSVDMyVBOWxpb3JhdGlvbiUyMHZpc3VlbGxlJTIwZXN0JTIwJTNDc3Ryb25nJTNFdmFyaWFibGUlMkMlM0MlMkZzdHJvbmclM0UlMjBldCUyMGQlQzMlQTlwZW5kcmElMjBkZSUyMGwlRTIlODAlOTlhbmNpZW5uZXQlQzMlQTklMjBldCUyMGRlJTIwbGElMjB0YWlsbGUlMjBkdSUyMHRyb3UlMjBtYWN1bGFpcmUlMkMlMjBkZSUyMGwlRTIlODAlOTlvYnRlbnRpb24lMjBvdSUyMG5vbiUyMGRlJTIwbGElMjBmZXJtZXR1cmUlMjBkdSUyMHRyb3UlMjBtYWN1bGFpcmUlMkMlMjBhaW5zaSUyMHF1ZSUyMGRlcyUyMCVDMyVBOXZlbnR1ZWxsZXMlMjBhdXRyZXMlMjBsJUMzJUE5c2lvbnMlMjBvY3VsYWlyZXMuJTIwJTNDJTJGcCUzRSUwQSUwQSUzQ3AlMjBjbGFzcyUzRCUyMnBhcmFnJTIyJTNFTCVFMiU4MCU5OWFjdWl0JUMzJUE5JTIwdmlzdWVsbGUlMjBlc3QlMjBnJUMzJUE5biVDMyVBOXJhbGVtZW50JTIwJTNDc3Ryb25nJTNFc3RhYmlsaXMlQzMlQTllJTIwYXUlMjBib3V0JTIwZGUlMjA2JTIwbW9pcy4lM0MlMkZzdHJvbmclM0UlM0MlMkZwJTNFJTBBJTBBJTNDcCUyMGNsYXNzJTNEJTIycGFyYWclMjIlM0VQYXJmb2lzJTJDJTIwbGElMjBjb3JyZWN0aW9uJTIwcGFyJTIwbHVuZXR0ZXMlMjBzZSUyMG1vZGlmaWUlMjAlM0NzdHJvbmclM0VhdSUyMGNvdXJzJTIwZGVzJTIwbW9pcyUyMHF1aSUyMHN1aXZlbnQlMjBsJUUyJTgwJTk5aW50ZXJ2ZW50aW9uJTJDJTIwZXQlMjB1bmUlMjBub3V2ZWxsZSUyMHByZXNjcmlwdGlvbiUyMHNlcmElMjBkJUMzJUE5bGl2ciVDMyVBOWUlMjBsZSUyMGNhcyUyMCVDMyVBOWNoJUMzJUE5YW50LiUzQyUyRnAlM0UlMEElMEElM0NwJTIwY2xhc3MlM0QlMjJwYXJhZyUyMiUzRVNpJTIwbGElMjBjYXRhcmFjdGUlMjBuJUUyJTgwJTk5YSUyMHBhcyUyMCVDMyVBOXQlQzMlQTklMjBvcCVDMyVBOXIlQzMlQTllJTJDJTIwZWxsZSUyMHN1cnZpZW50JTIwdHIlQzMlQThzJTIwc291dmVudCUyMGF1JTIwY291cnMlMjBkZXMlMjBtb2lzJTIwb3UlMjBhbm4lQzMlQTllcyUyMHN1aXZhbnQlMjBsJUUyJTgwJTk5aW50ZXJ2ZW50aW9uJTIwY2hpcnVyZ2ljYWxlLiUzQyUyRnN0cm9uZyUzRSUyMEVsbGUlMjBuJUMzJUE5Y2Vzc2l0ZXJhJTIwYWxvcnMlMjBkJUUyJTgwJTk5JUMzJUFBdHJlJTIwb3AlQzMlQTlyJUMzJUE5ZSUyMCVDMyVBMCUyMHNvbiUyMHRvdXIuJTNDJTJGcCUzRQ==
Effets indésirables et complications potentielles
JTNDcCUyMGNsYXNzJTNEJTIycGFyYWclMjIlM0VMYSUyMGNoaXJ1cmdpZSUyMGR1JTIwdHJvdSUyMG1hY3VsYWlyZSUyMGVzdCUyMHVuZSUyMGludGVydmVudGlvbiUyMGNoaXJ1cmdpY2FsZSUyMGZyJUMzJUE5cXVlbW1lbnQlMjBwcmF0aXF1JUMzJUE5ZSUyMGNoYXF1ZSUyMGFubiVDMyVBOWUlMjBlbiUyMEZyYW5jZS4lMjBDZXR0ZSUyMG9wJUMzJUE5cmF0aW9uJTIwZXN0JTIwcyVDMyVCQnJlJTIwZXQlMjBlZmZpY2FjZS4lMjBJbCUyMG4lMjdleGlzdGUlMjBjZXBlbmRhbnQlMjBwYXMlMjBkZSUyMGNoaXJ1cmdpZSUyMHNhbnMlMjByaXNxdWUuJTIwSWwlMjBuJTI3ZXN0JTIwZG9uYyUyMHBhcyUyMHBvc3NpYmxlJTIwZGUlMjBnYXJhbnRpciUyMGZvcm1lbGxlbWVudCUyMGxlJTIwc3VjYyVDMyVBOHMlMjBkZSUyMGwlMjdpbnRlcnZlbnRpb24lMkMlMjBtJUMzJUFBbWUlMjBzaSUyMGNlbHVpLWNpJTIwZXN0JTIwY29uc2lkJUMzJUE5ciVDMyVBOSUyMGNvbW1lJTIwaGFiaXR1ZWwuJTNDJTJGcCUzRSUwQSUwQSUzQ2gzJTNFQ29tcGxpY2F0aW9ucyUyMHBlbmRhbnQlMjBsJUUyJTgwJTk5aW50ZXJ2ZW50aW9uJTIwJTNDJTJGaDMlM0UlMEElM0NwJTNFTGVzJTIwaW5jaWRlbnRzJTIwcGVuZGFudCUyMGwlRTIlODAlOTlvcCVDMyVBOXJhdGlvbiUyMHNvbnQlMjByYXJlcyUyMGV0JTIwaW1wciVDMyVBOXZpc2libGVzLiUyMExlJTIwZCVDMyVBOXJvdWxlbWVudCUyMGRlJTIwbCUyN2ludGVydmVudGlvbiUyMHBldXQlMjAlQzMlQUF0cmUlMjBjb21wbGlxdSVDMyVBOSUyQyUyMHVuZSUyMGF0dGVpbnRlJTIwZHUlMjBjcmlzdGFsbGluJTJDJTIwdW5lJTIwZCVDMyVBOWNoaXJ1cmUlMjByJUMzJUE5dGluaWVubmUlMkMlMjB1biUyMGQlQzMlQTljb2xsZW1lbnQlMjBkZSUyMGxhJTIwciVDMyVBOXRpbmUuJTIwVW5lJTIwaCVDMyVBOW1vcnJhZ2llJTIwcGV1dCUyMHNlJTIwcHJvZHVpcmUlMjBldCUyMHNlJTIwciVDMyVBOXNvcmJlJTIwZW4lMjBnJUMzJUE5biVDMyVBOXJhbCUyMGVuJTIwcXVlbHF1ZXMlMjBqb3VycyUyMGRhbnMlMjBkZXMlMjBjYXMlMjB0ciVDMyVBOHMlMjBleGNlcHRpb25uZWxzJTJDJTIwbW9pbnMlMjBkJUUyJTgwJTk5dW4lMjBjYXMlMjBzdXIlMjAxMDAlMjAwMDAlMkMlMjBlbGxlJTIwcGV1dCUyMGFib3V0aXIlMjAlQzMlQTAlMjBsYSUyMHBlcnRlJTIwZGUlMjBsYSUyMHZpc2lvbiUyQyUyMHZvaXJlJTIwJUMzJUEwJTIwbGElMjBwZXJ0ZSUyMGRlJTIwbCUyNyVDNSU5M2lsLiUzQyUyRnAlM0UlMEElMEElMEElM0NoMyUzRUNvbXBsaWNhdGlvbnMlMjBhcHIlQzMlQThzJTIwbCVFMiU4MCU5OWludGVydmVudGlvbiUzQyUyRmgzJTNFJTBBJTNDcCUzRUVsbGVzJTIwcGV1dmVudCUyMCVDMyVBQXRyZSUyMGclQzMlQTluJUMzJUE5cmFsZW1lbnQlMjB0cmFpdCVDMyVBOWVzJTIwc2FucyUyMGFsdCVDMyVBOXJlciUyMGxlJTIwcHJvbm9zdGljJTIwZm9uY3Rpb25uZWwlMjBvdSUyMGFuYXRvbWlxdWUlMjBkZSUyMGwlRTIlODAlOTklQzUlOTNpbCUyQyUyMGF2ZWMlMjBwYXJmb2lzJTIwY2VwZW5kYW50JTIwdW5lJTIwYXVnbWVudGF0aW9uJTIwZHUlMjBkJUMzJUE5bGFpJTIwZGUlMjByJUMzJUE5Y3VwJUMzJUE5cmF0aW9uJTIwZGUlMjBsYSUyMHZpc2lvbi4lM0MlMkZwJTNFJTBBJTNDcCUyMGNsYXNzJTNEJTIyYXZhbnQtdWwlMjIlM0VPbiUyMHBldXQlMjBjaXRlciUyMG5vdGFtbWVudCUyMCUzQSUzQyUyRnAlM0UlMEElM0N1bCUzRSUwQSUzQ2xpJTNFVW5lJTIwY2F0YXJhY3RlJTJDJTIwY29tcGxpY2F0aW9uJTIwbGElMjBwbHVzJTIwZnIlQzMlQTlxdWVudGUlM0MlMkZsaSUzRSUwQSUzQ2xpJTNFRWNjaHltb3NlJTIwZHUlMjBibGFuYyUyMGRlJTIwbCUyNyVDNSU5M2lsJTIwb3UlMjBkZSUyMGxhJTIwcGF1cGklQzMlQThyZSUzQyUyRmxpJTNFJTBBJTNDbGklM0VDaHV0ZSUyMHBhcnRpZWxsZSUyMGRlJTIwbGElMjBwYXVwaSVDMyVBOHJlJTIwc3VwJUMzJUE5cmlldXJlJTNDJTJGbGklM0UlMEElM0NsaSUzRUluZmxhbW1hdGlvbiUyMHRyYW5zaXRvaXJlJTIwZGUlMjBsJTI3JUM1JTkzaWwlMjAlMjhyb3VnZXVyJTJDJTIwc2Vuc2F0aW9uJTIwZGUlMjBzYWJsZSUyMGRhbnMlMjBsJUUyJTgwJTk5JUM1JTkzaWwlMjklM0MlMkZsaSUzRSUwQSUzQ2xpJTNFUGVyY2VwdGlvbiUyMGRlJTIwbW91Y2hlcyUyMHZvbGFudGVzJTNDJTJGbGklM0UlMEElM0NsaSUzRUF1Z21lbnRhdGlvbiUyMGRlJTIwbGElMjBwcmVzc2lvbiUyMGludHJhb2N1bGFpcmUlM0MlMkZsaSUzRSUwQSUzQyUyRnVsJTNFJTBBJTBBJTBBJTNDaDMlM0VMZXMlMjBjb21wbGljYXRpb25zJTIwcyVDMyVBOXYlQzMlQThyZXMlMjBkZSUyMGwlRTIlODAlOTlvcCVDMyVBOXJhdGlvbiUyMGR1JTIwdHJvdSUyMG1hY3VsYWlyZSUyMHNvbnQlMjB0ciVDMyVBOHMlMjByYXJlcy4lM0MlMkZoMyUzRSUwQSUzQ3AlM0VFbGxlcyUyMHBldXZlbnQlMjBuJUMzJUE5Y2Vzc2l0ZXIlMjB1bmUlMjByJUMzJUE5LWludGVydmVudGlvbiUyMGV0JTIwYWJvdXRpciUyQyUyMGRhbnMlMjBsZXMlMjBjYXMlMjBsZXMlMjBwbHVzJTIwZXh0ciVDMyVBQW1lcyUyQyUyMCVDMyVBMCUyMGxhJTIwcGVydGUlMjBkZSUyMHRvdXRlJTIwdmlzaW9uJTIwZGUlMjBsJTI3JUM1JTkzaWwlMjBvcCVDMyVBOXIlQzMlQTklMkMlMjB2b2lyZSUyMCVDMyVBMCUyMGxhJTIwcGVydGUlMjBkZSUyMGwlMjclQzUlOTNpbCUyMGx1aS1tJUMzJUFBbWUuJTNDJTJGcCUzRSUwQSUzQ3AlMjBjbGFzcyUzRCUyMmF2YW50LXVsJTIyJTNFTGVzJTIwY29tcGxpY2F0aW9ucyUyMHMlQzMlQTl2JUMzJUE4cmVzJTIwc29udCUyMGxlcyUyMHN1aXZhbnRlcyUyMCUzQSUzQyUyRnAlM0UlMEElM0N1bCUzRSUwQSUzQ2xpJTNFQWx0JUMzJUE5cmF0aW9uJTIwZGUlMjBsYSUyMG1hY3VsYSUzQyUyRmxpJTNFJTBBJTNDbGklM0VJbmZlY3Rpb24lMjBhbm5vbmMlQzMlQTllJTIwcGFyJTIwdW5lJTIwZG91bGV1ciUyMHMlRTIlODAlOTlhZ2dyYXZhbnQlMjBldCUyMHVuZSUyMGJhaXNzZSUyMGRlJTIwdmlzaW9uJTIwc3VydmVuYW50JTIwMiUyMCVDMyVBMCUyMDQlMjBqb3VycyUyMGFwciVDMyVBOHMlMjBsJUUyJTgwJTk5b3AlQzMlQTlyYXRpb24lMkMlMjBuJUMzJUE5Y2Vzc2l0YW50JTIwdW4lMjB0cmFpdGVtZW50JTIwdXJnZW50JTNDJTJGbGklM0UlMEElM0NsaSUzRVRyYXVtYXRpc21lJTIwZGUlMjBsJTI3JUM1JTkzaWwlMjBwYXIlMjBsZSUyMHBhdGllbnQlMjBvdSUyMHNvbiUyMGVudG91cmFnZSUzQyUyRmxpJTNFJTBBJTNDbGklM0VEJUMzJUE5Y2hpcnVyZSUyMHIlQzMlQTl0aW5pZW5uZSUyMGV0JTIwZCVDMyVBOWNvbGxlbWVudCUyMGRlJTIwbGElMjByJUMzJUE5dGluZSUyQyUyMHBvdXZhbnQlMjBzdXJ2ZW5pciUyMGFwciVDMyVBOHMlMjBsJUUyJTgwJTk5aW50ZXJ2ZW50aW9uJTIwdm9pcmUlMjBhcHIlQzMlQThzJTIwcGx1c2lldXJzJTIwYW5uJUMzJUE5ZXMlMkMlMjBldCUyMGZhdm9yaXMlQzMlQTklMjBwYXIlMjBkZXMlMjBmYWN0ZXVycyUyMGRlJTIwcmlzcXVlJTIwaW5kaXZpZHVlbHMlMkMlMjAxJTIwY2FzJTIwc3VyJTIwMTAwJTIwZW52aXJvbiUyQyUyMG4lQzMlQTljZXNzaXRhbnQlMjB1bmUlMjBpbnRlcnZlbnRpb24lMjB1cmdlbnRlJTIwYXlhbnQlMjBlbnZpcm9uJTIwOTAlMjAlMjUlMjBkZSUyMHN1Y2MlQzMlQThzJTNDJTJGbGklM0UlMEElM0NsaSUzRUFtcHV0YXRpb24lMjBkdSUyMGNoYW1wJTIwdmlzdWVsJTNDJTJGbGklM0UlMEElM0NsaSUzRSVDNSU5MmQlQzMlQThtZSUyMHIlQzMlQTl0aW5pZW4lMjBjZW50cmFsJTJDJTIwMSUyMCUyNSUyMGRlcyUyMGNhcyUyQyUyMHNvdXZlbnQlMjByJUMzJUE5c29sdXRpZiUyMGVuJTIwcXVlbHF1ZXMlMjBzZW1haW5lcyUzQyUyRmxpJTNFJTBBJTNDbGklM0VQaG90by10cmF1bWF0aXNtZSUyMCUyOGJyJUMzJUJCbHVyZSUyMHIlQzMlQTl0aW5pZW5uZSUyOSUzQyUyRmxpJTNFJTBBJTNDJTJGdWwlM0UlMEE=


